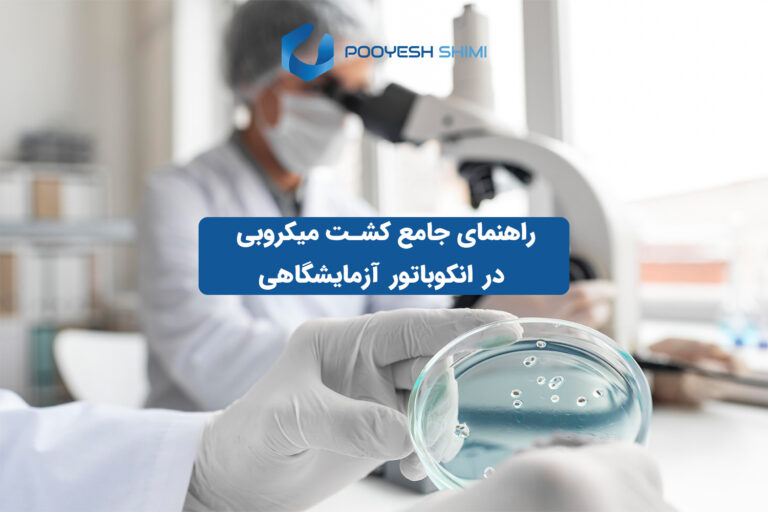

نکات راه اندازی آزمایشگاه شامل چه مواردی می شود و چرا توجه به آن ها اهمیت دارد؟ این نکات شامل…

چگونه عدم کالیبراسیون و خطاهای نتایج آزمایش می تواند بر دقت نتایج علمی تأثیر بگذارد؟ عدم کالیبراسیون و خطاهای نتایج…

عوامل آلودگی محیط کشت چه تأثیری بر کیفیت محصولات کشاورزی دارند؟ عوامل آلودگی محیط کشت می توانند سلامت گیاهان را…

تفاوت تجهیزات آزمایشگاهی تحقیقاتی و صنعتی ! در دنیای امروز، آزمایشگاه ها نقش قلب تپنده توسعه علمی و صنعتی را…

تفاوت هات پلیت و همزن مغناطیسی ! در فضای واقعی آزمایشگاه، هیچ چیز به اندازه «کنترل شرایط» اهمیت ندارد. دما،…

میکروتیوب چیست؟ در آزمایشگاه های شیمی، زیست شناسی، ژنتیک، بیوتکنولوژی و تشخیص طبی، بخش زیادی از آزمایش ها روی حجم…

مقایسه پیپت دستی و الکترونیکی ! در بسیاری از آزمایشگاه های تحقیقاتی، تشخیصی و صنعتی، پیپت یکی از پرکاربردترین ابزارها…

دستگاه های آزمایشگاهی برای تحقیقات ! در جهان پرشتاب علم و فناوری، فاصله میان یک ایده خام و یک محصول…

شستشوی صحیح رک لوله آزمایش استیل ! در محیط های آزمایشگاهی، تجهیزات بهداشتی و دقیق از اهمیت ویژه ای برخوردارند.…

نکات کلیدی خرید شیشه آلات آزمایشگاهی ! شیشه آلات آزمایشگاهی از مهم ترین و پایه ایترین تجهیزات هر آزمایشگاه محسوب…

انتخاب گیلاس مدرج مناسب برای آزمایش! در آزمایشگاه ها، دقت و صحت اندازه گیری ها نقش اساسی در دستیابی به…

انتخاب بهترین نوع همزن آزمایشگاهی ! برای آزمایشگاه شما میتواند تأثیر زیادی در دقت و کیفیت نتایج داشته باشد. با…

کاهش خطای انسانی در آزمایشگاه ! خطای انسانی یکی از رایج ترین دلایل بروز اشتباهات در محیط های آزمایشگاهی است؛…

در صنایع غذایی، حفظ کیفیت، طعم، ماندگاری و ایمنی محصول، تنها به انتخاب مواد اولیه یا طراحی فرمولاسیون ختم نمی…

کالیبراسیون چیست ؟ دستگاه های آزمایشگاهی، ستون اصلی تولید داده های علمی دقیق هستند؛ اما بسیاری از آزمایشگاه ها تنها…

آزمایشگاه محیطی علمی و تخصصی است که در آن واکنش های شیمیایی، بیولوژیکی و فیزیکی انجام می شود. همین ماهیت…

فتومتر آب یکی از پرکاربرد ترین ابزارهای آزمایشگاهی و صنعتی در حوزه آنالیز کیفیت آب است. این دستگاه با استفاده…
راهنمای جامع کشت میکروبی در انکوباتور آزمایشگاهی کشت میکروبی به فرآیند فراهم کردن شرایط کنترل شده برای رشد میکروارگانیسم ها…